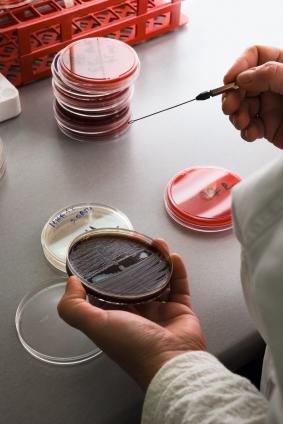

Group B Strep
Group B strep is an illness that can cause major complications in a newborn, including the possibility of death. If a newborn is diagnosed within the first week of birth with Group B strep, it is often accompanied by pneumonia. Group B strep diagnosed after the first week is often accompanied by meningitis. Pregnant women are normally checked for this disease during their 36 week checkup. The vagina and rectum are swabbed and if the woman tests positive, she is given medications, either orally or through IV. Receiving the IV medication immediately before birth has also been associated with a decreased risk in the child being born with Group B strep.
A baby born with Group B strep may appear blue in color, have difficulty breathing, have an irregular heart beat and have an unstable body temperature. Doctors can test the baby’s blood for Group B strep. In addition to the mother having tested positive for the disease, other risk factors include early birth, the mother having a fever during birth, long labor, and the use of a scalp lead during labor. If timely diagnosed with Group B strep, a Baby can be successfully with medications, respiratory treatments, and if necessary oxygen therapy, among other remedies.
Do you have questions about this post or an alarming medical condition occurring before or after birth? Contact us today.